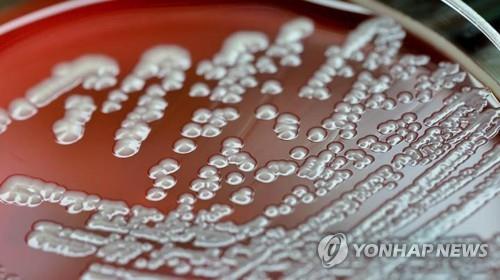

英 연구팀 "사후 작동하는 박테리아 효소, 자기 몸 분해해 주변 세포 도와"
(서울=연합뉴스) 이주영 기자 = 한 대장균(E-coli) 박테리아에서 죽은 후 작동하면서 세포 내용물을 영양분으로 분해해 주변에 있는 박테리아가 이를 잘 흡수하도록 돕는 효소가 발견됐다.
연구진은 이는 생존이 아닌 사후를 위한 진화가 일어날 수 있음을 보여주는 것이라며 진화와 죽음을 바라보는 관점을 다시 생각하게 한다고 말했다.
영국 더럼대 마틴 캔 교수팀은 22일 과학 저널 네이처 커뮤니케이션(Nature Communications)에서 대장균 박테리아의 한 종류가 죽은 후 세포 내용물을 영양분으로 분해하는 효소를 만든다는 사실을 발견했다고 밝혔다.
다윈의 자연 선택설은 생명체가 생존과 번식에 도움이 되는 형질을 획득하는 과정을 설명한다. 이 때문에 죽음은 진화에 의해 형성된 과정이라기보다는 진화의 실패로 여겨지는 경우가 많다.
하지만 생명체가 죽으면 분해되면서 다른 생명체의 영양분으로 재활용되기 때문에 생태계 측면에서는 죽음도 생명을 유지하는 중요한 과정이다.
연구팀은 이 연구에서 초음파 처리에 의해 죽은 대장균의 세포 물질(용해물.lysate)을 이용해 박테리아가 죽은 후 방출되는 '론 단백질 분해효소'(Lon protease)의 역할을 분석했다.
그 결과 론 단백질 분해효소가 있는 박테리아의 단백질은 분해돼 주변의 다른 대장균들이 잘 흡수해 성장에 활용하는 것으로 나타났다.
그러나 론 단백질 분해효소가 없는 유전자 조작 박테리아의 용해물은 잘 분해되지 않아 주변 박테리아들의 성장에 도움이 되지 못했다.
캔 교수는 "죽은 세포에서 영양분을 얻는 이웃 박테리아들은 죽은 박테리아와 유전적으로 관련돼 있을 가능성이 높다"며 결과적으로 이는 죽은 세포가 친척 세포에 영양분을 공급하는 셈이라고 설명했다.
논문 공동 저자인 옥스퍼드대 스튜어트 웨스트 교수는 "이것은 이전에 관찰한 적이 없는 일"이라며 "죽은 미어캣이 갑자기 다른 미어캣들이 먹을 수 있는 삶은 달걀 더미로 변하는 것과 같다"고 말했다.
연구팀은 이 발견은 생전 과정과 마찬가지로 죽음 이후 과정도 생물학적으로 프로그램화돼 진화의 대상이 될 수 있음을 보여준다며 사후 과정을 조절하는 생체 분자는 향후 박테리아 질병 연구나 생명공학에 활용될 수 있을 것이라고 밝혔다.
캔 교수는 "이 연구는 죽음이 프로그램화된 생물학적 과정의 끝이 아님을 보여주며 이런 과정은 죽음 후에도 계속되고 그렇게 되도록 진화한 것"이라며 "이 연구는 생명체의 진화와 죽음에 대한 관점을 근본적으로 다시 생각하게 한다"고 말했다.
◆ 출처 : Nature Communications, Martin J. Cann et al., 'Bacteria encode post-mortem protein catabolism that enables altruistic nutrient recycling', https://www.nature.com/articles/s41467-025-56761-6
scitech@yna.co.kr
(끝)
<저작권자(c) 연합뉴스, 무단 전재-재배포, AI 학습 및 활용 금지>
관련뉴스







